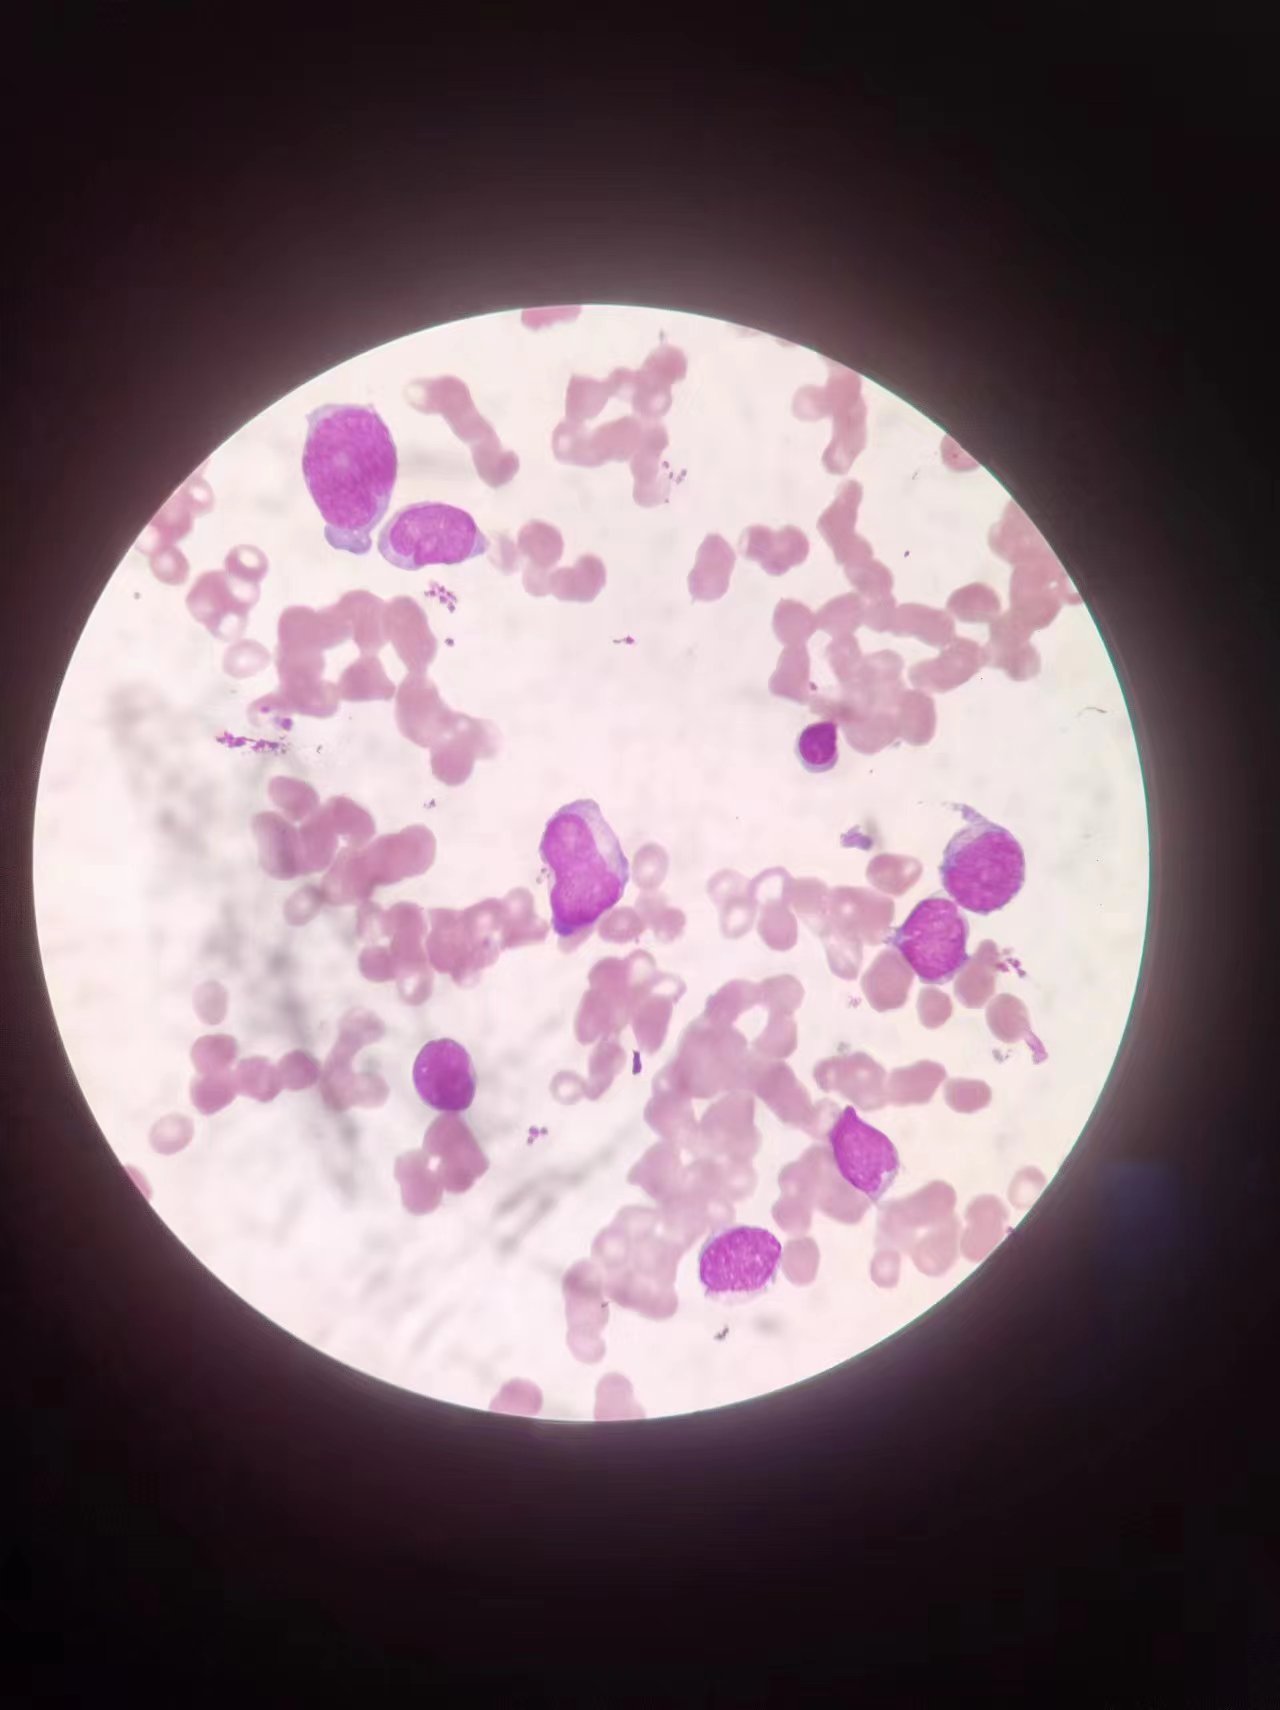

“哎哟、哎哟...”,这声音来自于一位躺在血液科门诊室床上的老大爷,医生仔细检查后,就与我联系,先查个血常规及推个片看看外周血的情况。
血常规结果如下图:
外周血涂片发现异常细胞,考虑为原始幼稚细胞
告知医生后,遂住院进一步检查。
骨穿结果如图:
综合外周及骨髓,形态是考虑急性白血病的。随后通过流式技术做的免疫分型结果也出来了,如下图:


免疫分型结果是急性髓系白血病。
下面是遗传学的染色体结果:

染色体核型是包括8号染色体片段和21号染色体片段移位的复杂核型,
分子生物学结果如图:


发现ETO融合基因及两种基因突变。至此MICM检查完毕,该病例最后诊断为急性髓系白血病伴AML1-ETO、IDH1、DNMT3A阳性。
近年来,生物标记技术、流式细胞术、体外基因扩增技术、生物芯片技术、床边快速检验方法等免疫学,细胞生物学、分子生物学技术飞速发展,其在血液检验领域的应用日趋广泛,对实验血液学,临床血液学以及血液学检验技术的进步起到了巨大的推动作用。
如人类白细胞抗原的发现和检测方法的建立极大地推动干细胞异基因移植技术和干细胞研究的快速发展;单克隆抗体制备技术的发明给血液学的发展带来了新的生机,白血病开始了免疫分型,使血液病的诊断和治疗水平得以显著提升。
单克隆抗体产品开始广泛用于血液学基础研究和临床血液病的诊断;在单克隆抗体制备技术基础上发展的流式细胞术有力地推动细胞增殖动力学、肿瘤细胞生物学、血液学的基础和临床研究的发展;分子生物学技术和细胞遗传学技术的发展造就了现代分子血液学,生物信息学、基因组学、蛋白质组学和基因芯片技术等的出现,引起血液学检验技术发生了革命性的变化,血液学检验不断被赋予新的内涵,实验项目逐渐增多,检测技术和手段日新月异,所提供的信息数量也成倍增长,血液检验在血液病的预防、诊断、治疗和预后中发挥越来越重要的作用。
FAB经过几十年不断的修改和完善,基于细胞形态学(morphology)、结合免疫学(immunology)、细胞遗传学(cytogenetics)特点,提出了 MIC 分类方案。随后,很快在MIC分型的基础上结合分子生物学(molecular biology),提出了更为全面的 MICM 分型,为临床白血病治疗和预后观察提供了更有利的实验数据。
(医学检验科 孙伟娜)